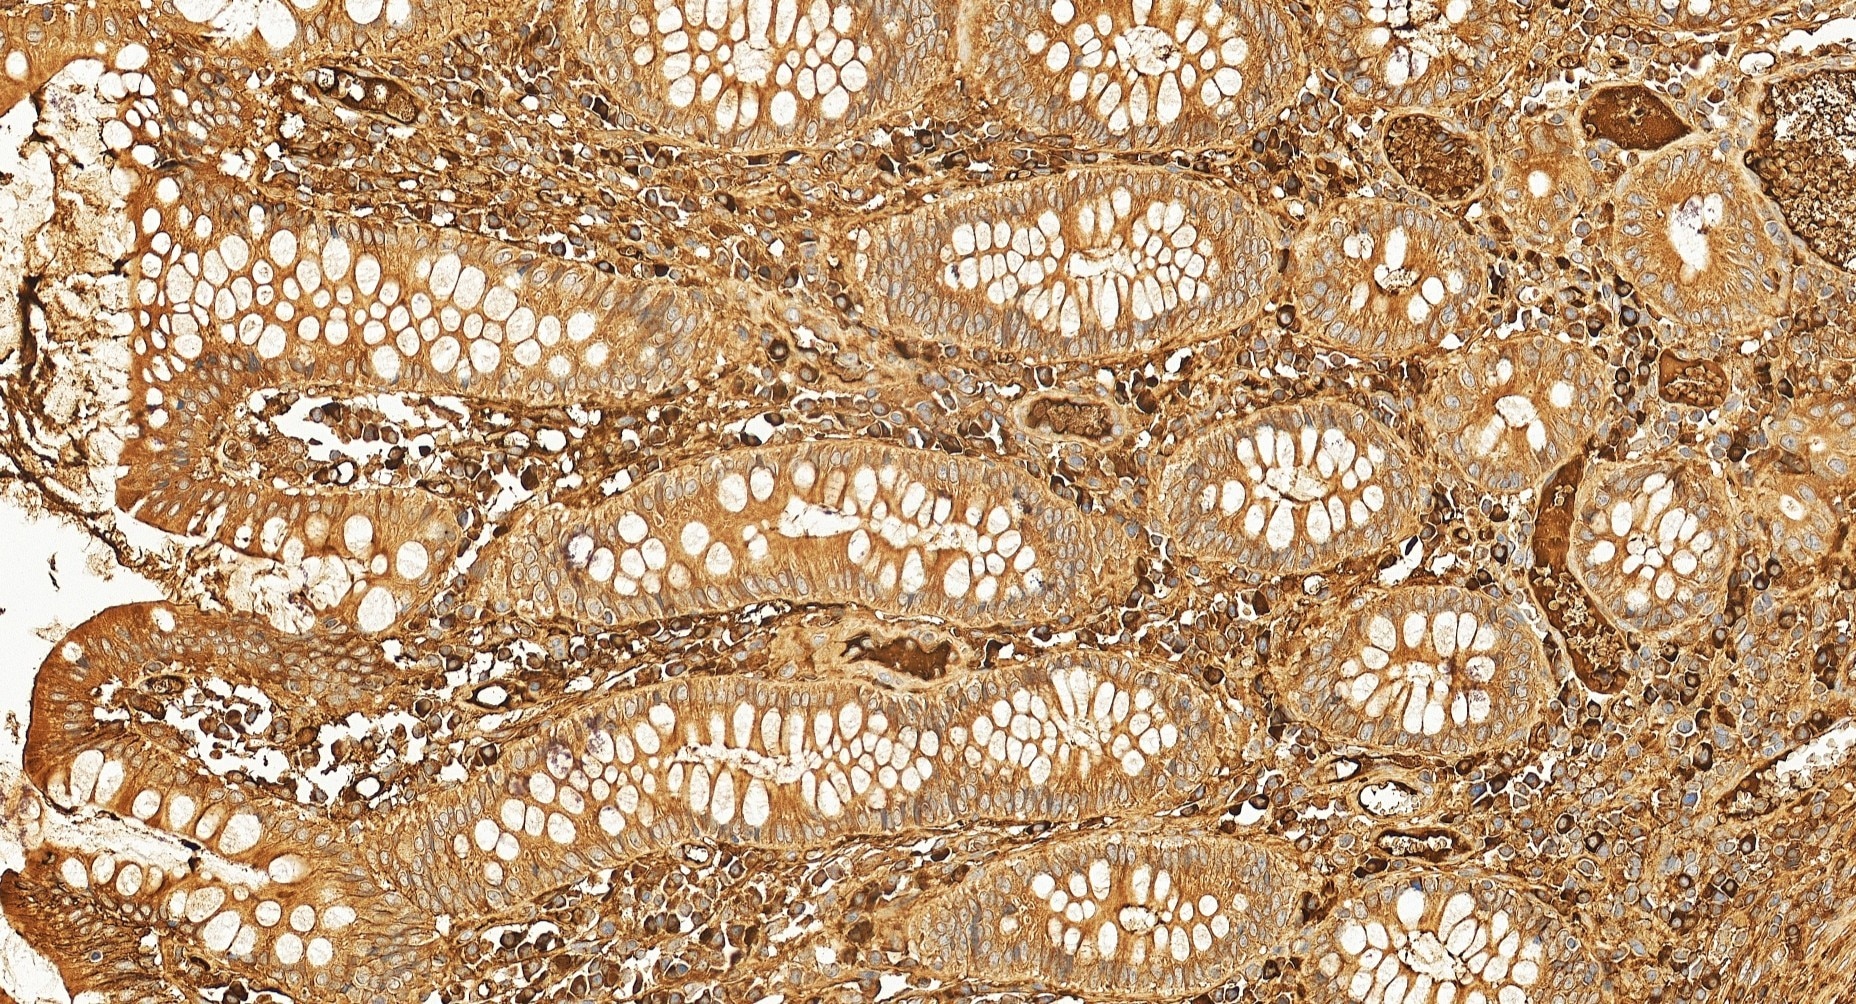
IHC staining of human colon cancer using 11271-1-AP Immunohistochemistry (IHC) staining of human colon cancer tissue using RPL13 Polyclonal antibody (11271-1-AP)

Tested Applications
| Positive WB detected in | HeLa cells, SGC-7901 cells, human lung tissue |
| Positive IHC detected in | human colon cancer tissue Note: suggested antigen retrieval with TE buffer pH 9.0; (*) Alternatively, antigen retrieval may be performed with citrate buffer pH 6.0 |
Recommended dilution
| Application | Dilution |
|---|---|
| Western Blot (WB) | WB : 1:500-1:1000 |
| Immunohistochemistry (IHC) | IHC : 1:50-1:500 |
| It is recommended that this reagent should be titrated in each testing system to obtain optimal results. | |
| Sample-dependent, Check data in validation data gallery. | |
Published Applications
| WB | See 4 publications below |
| IF | See 2 publications below |
Product Information
11271-1-AP targets RPL13 in WB, IHC, IF, ELISA applications and shows reactivity with human, mouse, rat samples.
| Tested Reactivity | human, mouse, rat |
| Cited Reactivity | human, mouse |
| Host / Isotype | Rabbit / IgG |
| Class | Polyclonal |
| Type | Antibody |
| Immunogen |
CatNo: Ag1814 Product name: Recombinant human RPL13 protein Source: e coli.-derived, PGEX-4T Tag: GST Domain: 1-166 aa of BC014167 Sequence: MAPSRNGMVLKPHFHKDWQRRVATWFNQPARKIRRRKARQAKARRIAPRPASGPIRPIVRCPTVRYHTKVRAGRGFSLEELRVAGIHKKVARTIGISVDPRRRNKSTESLQANVQRLKEYRSKLILFPRKPSAPKKGDSSAEELKLATQLTGPVMPVRNVYKKEKA Predict reactive species |
| Full Name | ribosomal protein L13 |
| Calculated Molecular Weight | 24 kDa |
| Observed Molecular Weight | 24 kDa |
| GenBank Accession Number | BC014167 |
| Gene Symbol | RPL13 |
| Gene ID (NCBI) | 6137 |
| RRID | AB_2269735 |
| Conjugate | Unconjugated |
| Form | Liquid |
| Purification Method | Antigen affinity purification |
| UNIPROT ID | P26373 |
| Storage Buffer | PBS with 0.02% sodium azide and 50% glycerol, pH 7.3. |
| Storage Conditions | Store at -20°C. Stable for one year after shipment. Aliquoting is unnecessary for -20oC storage. 20ul sizes contain 0.1% BSA. |
Background Information
The mammalian ribosome comprises 79 ribosomal proteins and four rRNAs, which combine in equimolar ratios to form the small (40S) and large (60S) subunits. Ribosome proteins are a direct and critical target of the PI3K pathway in promoting growth.[PMID:15289434]. RPL13 may be a plausible candidate tumor suppressor gene, as knocking down L13 expression using small interfering RNA (siRNA) resulted in drastic attenuation of cancer cell growth with significant G1 and G2/M arrest of the cell cycle[PMID:16786168].
Protocols
| Product Specific Protocols | |
|---|---|
| IHC protocol for RPL13 antibody 11271-1-AP | Download protocol |
| WB protocol for RPL13 antibody 11271-1-AP | Download protocol |
| Standard Protocols | |
|---|---|
| Click here to view our Standard Protocols |
Publications
| Species | Application | Title |
|---|---|---|
Cell Res Pre-ribosomal RNA reorganizes DNA damage repair factors in nucleus during meiotic prophase and DNA damage response. | ||
Ecotoxicol Environ Saf ZEA and DON inhibited inflammation after L. monocytogenes infection and induced ribosomal hyperfunction. | ||
Mol Cell Proteomics Proteomic landscape of exosomes reveals the functional contributions of CD151 in triple-negative breast cancer. | ||
Adv Sci (Weinh) m6A Reader hnRNPA2B1 Modulates Late Pachytene Progression in Male Meiosis Through Post-Transcriptional Control | ||
Cell Rep Single-nucleus profiling of mouse inner ear aging uncovers cell type heterogeneity and hair cell subtype-specific age-related signatures |